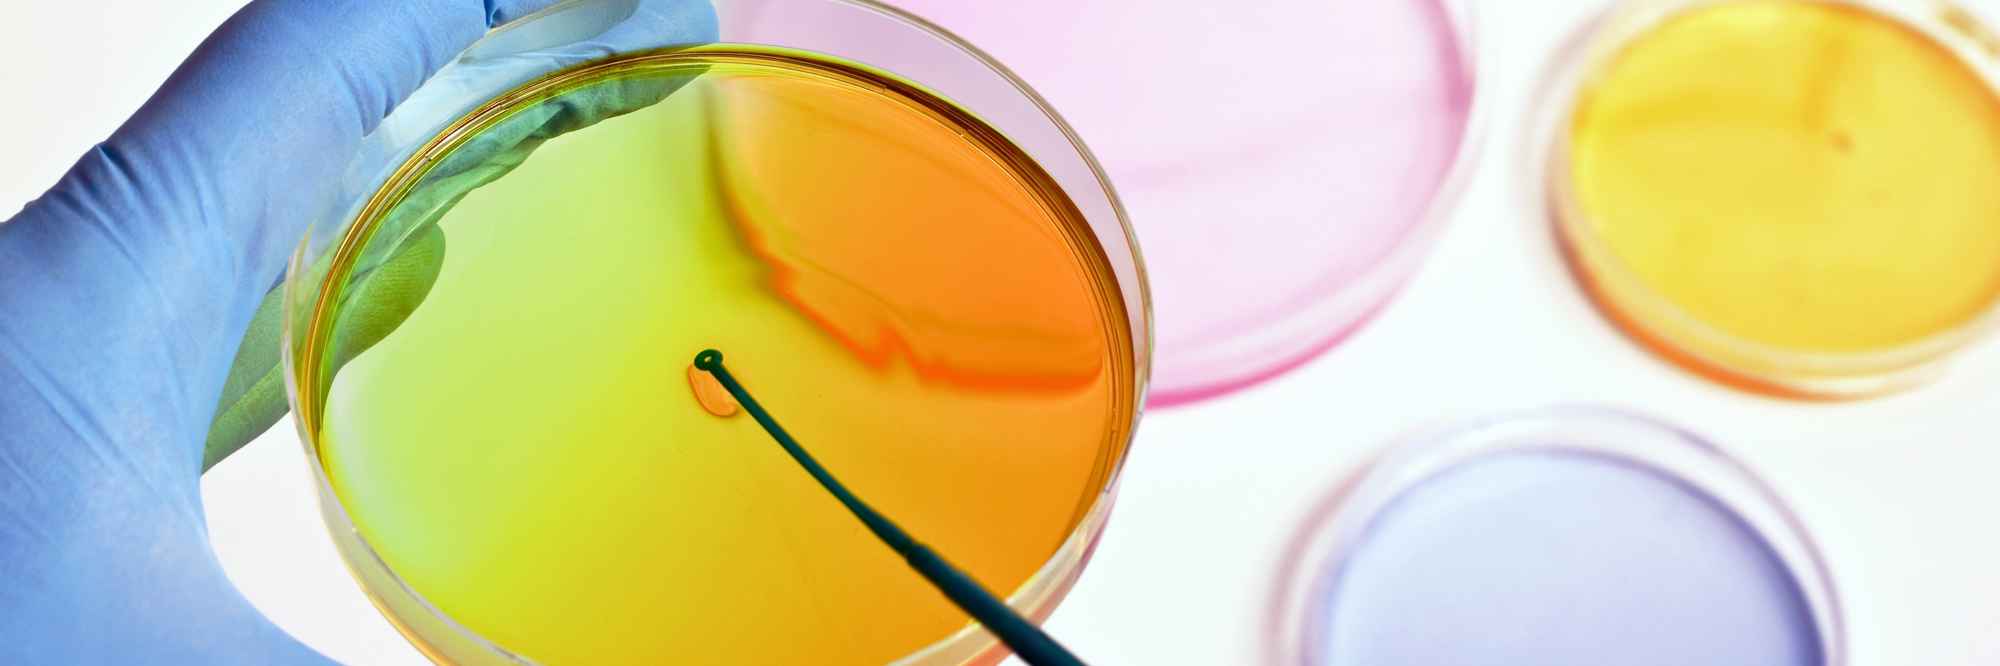

Stem cell therapy
What are stem cells?
Stem cells are cells that are naturally found in the body. These cells have the special ability of being able to form many different cell types. Researchers have also found ways of taking normal human cells, such as skin cells and turning them back into stem cells to become other cell types.
Scientists are hopeful that stem cells, and stem cell therapy may be able to play an important role to treat macular disease. Stem cells may be able to grow and replace lost or damaged cells in the eye that are responsible for vision loss in macular conditions.
What is stem cell therapy?
Stem cell therapy is the use of stem cells to replace dead or damaged cells in the body. This is a promising area of research for many diseases including macular disease.
Current research is looking at stem cell therapy for patients with vision loss due to wet or dry age-related macular degeneration (AMD). Clinical trials are underway both in the UK and abroad. Most notably, the London Project to Cure Blindness has tested stem cell therapy in patients with wet AMD. Read more on clinical trials.
Research is also underway in America for patients with dry AMD. All these studies are in very early stages. However, the results for those who have received stem cell therapy do seem very promising. Read more on this research.
We hope that in the future, stem cell therapy may be more widely available to patients. Although firstly it needs to be proven to be safe and effective.
Unlicensed stem cell clinics
Currently, stem cell therapy is not licensed for use as a treatment for AMD. However, this does not stop some clinics from offering it as a ‘treatment’. These clinics often rave about using the patient’s own cells (from blood or fat) and extracting stem cells. These cells are then injected into the patient’s eye. This is extremely dangerous.
These ‘treatments’ can have incredibly harmful side effects and cause complete blindness. This is because these cells, taken from the blood or fat, have not been reprogrammed to form eye cells. Instead, it is more likely they will become blood or fat cells. We do not recommend any patient undergo these treatments, as there is no proof they work and they can lead to complete loss of vision.
Where research is now
Information about new treatments such as stem cell and gene therapy, and how they can help people with macular disease.
Explore our research
Beating macular disease through funding medical research and improving the lives of those living with macular disease.
Get involved in research
Patients have a very important part to play in medical research. Without them we would not have the treatments we have today and new and improved treatments would not be possible.
Research news
The latest developments in the search for better treatments and a cure for macular disease.

Get the latest research news from the Macular Society
To hear about life-changing research and treatments, subscribe to our monthly enewsletter today. Together we can Beat Macular Disease.
Sign up to our free email newsletter